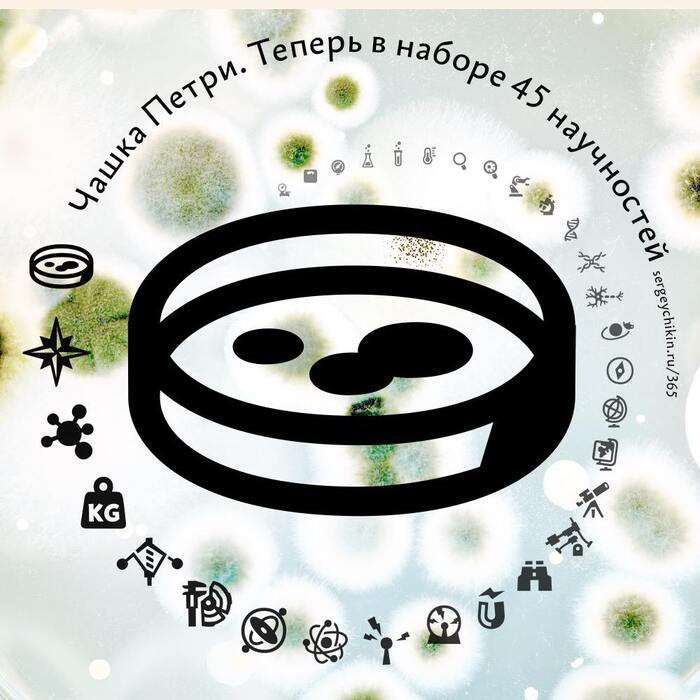
Почти ежедневная иконка — чашка Петри

Мухи являются переносчиками 351 типа бактерий
Исследование 2017 года, опубликованное в журнале Science Reports, показало, что комнатные мухи могут переносить примерно 351 тип бактерий.
Ответ на пост «Эксперимент с шариками»1
А это ли не упрощённая модель молнии?
Эксперимент с шариками1
Если вы возьмете чашку Петри, касторовое масло и несколько шариков и поместите все это в электрическое поле, вы можете заметить интересное поведение: самоорганизующиеся "провода", которые кажутся почти живыми.
tg: Научный Абсурд
Наглядная эволюция
Перед вами гигантская чашка Петри – блюдце с питательной средой для бактерий.
По краям – заметная белая масса – это бактерии (предположительно, кишечная палочка).
Пространство поделено на полосы, где заметно растет концентрация антибиотика (который эти бактерии, вроде как, должен убивать).
0, 1, 10, 100, и по центру — самая мощная концентрация — 1000.
Можно заметить, когда бактерии сталкиваются с первой полосой (концентрация 1) – выстраивается заметная стенка. Но потом эта стена "проламывается" — появляется первый мутант, который начинает размножаться дальше и дальше. Стенка проламывается в нескольких местах. Мутанты идут дальше и дальше, пока не оказываются в центре – где количество антибиотиков просто зашкаливающе. Теперь это количество для них – питательная среда :)
Вот вам наглядная работа эволюции – мутации + отбор.
Вот вам пример того, как неудержимо и многообразно (мутанты проявляются в разных местах, ведут себя по–разному) организм может преодолеть губительный барьер.
ЗЫ – именно поэтому, кстати, курс антибиотиков нужно пропивать до конца. Чтобы не допустить появления зловредных мутантов, которых мы усердно выводим всем человечеством вот уже много десятков лет.
(С) majakovskij
Где живут бактерии? (спойлер – везде)
Мы – группа начинающих ученых. Наши статьи пока не публикуют в Science, поэтому придется читать вам.
Гипотеза
Мой коллега оспаривал существование микроорганизмов (раз не видно, то их нет).
Эксперимент подтвердит их наличие (или отсутствие) в нашей квартире, а в случае обнаружения, покажет их излюбленные места.
Мы выбрали 5 мест:
туалет;
клавиатура;
телефон;
рот;
руки.
Если бактерии найдутся, нам кажется их должно быть больше в туалете, а меньше всего на руках. Проверим…
Проведение эксперимента
Стерилизуем чашки петри в духовке.
2. Делаем раствор агара и наполняем чашки петри так, чтобы он полностью закрыл дно. Оставляем раствор остывать пару минут, а потом отправляем чашки на час в холодильник, чтобы он как следует застыл.
3. Ковыряемся ватными палочками в разных местах, а потом трём ими по застывшему желе внутри чашек.
4. Заклеиваем чашки, переворачиваем, чтобы конденсат не испортил эксперимент и оставляем в теплом месте.
Одну оставили пустой чтобы проверить, качество эксперимента. Вдруг чашки плохо стерилизованы или палочки не стерильны.
Результаты эксперимента
Через 2 недели получили следующие результаты.
В контрольной баночке пусто, значит эксперимент прошел чисто.
Больше всего бактерий на клавиатуре. Тут же и самая страшно выглядящая коричневая плесень.
Меньше всего во рту. На первый взгляд кажется, что баночка пуста, но нет, тут встречаются уникальные «розовые шарики». Видимо среда рта очень отличается от прочих мест и бактерии тут совсем другие.
Всего обнаружилось 4 уникальных вида бактерий:
«черная плесень» – везде, кроме рта;
«коричневая плесень» – клавиатура;
«белая плесень» – туалет;
«розовые шарики» – рот.
Выводы
Микроорганизмы среди нас.
Во рту, из-за отличной от других мест среды, они совсем другие.
На технике бактерий больше чем даже в туалете.
Пойду продизенфицирую клавиатуру и телефон.
Грибная природа
Плодовое тело гриба - лишь маленькая его часть, что хорошо иллюстрирует этот гриб, выращенный в чашке Петри на питательной среде.
Большая его часть - это мицелий - вегетативное тело грибов, которое представляет собой переплетающиеся микроскопические нити (гифы), пронизывающие почву, древесину или другой субстрат.
Российские ученые выяснили, как можно защитить стройматериалы от плесневых грибов
Ученые из ННГУ им. Лобачевского, МГУ им. Н.П. Огарева и ПНИПУ оценили целесообразность защиты строительных материалов от биокоррозии при помощи синтетического вещества биоцида.
Исследователи напечатали на 3D-принтере специальные формы для заливки 1x1x3, которые наполнили раствором из бетона, цементного камня и гипсовой штукатурки, чтобы создать небольшие блоки. В некоторые образцы был добавлен биоцид.
Блоки поместили в стерильную чашку Петри, предварительно заразив их спорами плесневых грибов. Выяснилось, что сами по себе блоки оказались стойкими к действию грибов, но на их поверхность проявлялась плесень.
Задавшись целью сделать материалы фунгицидными (способными останавливать рост грибов), ученые провели еще один эксперимент.
Образцы, зараженные спорами плесневых грибов, также разместили в чашке Петри, но в этот раз создали в ней благоприятную атмосферу для их размножения. По информации Involta.media, в итоге вокруг образцов с биоцидом рост плесени не наблюдался.